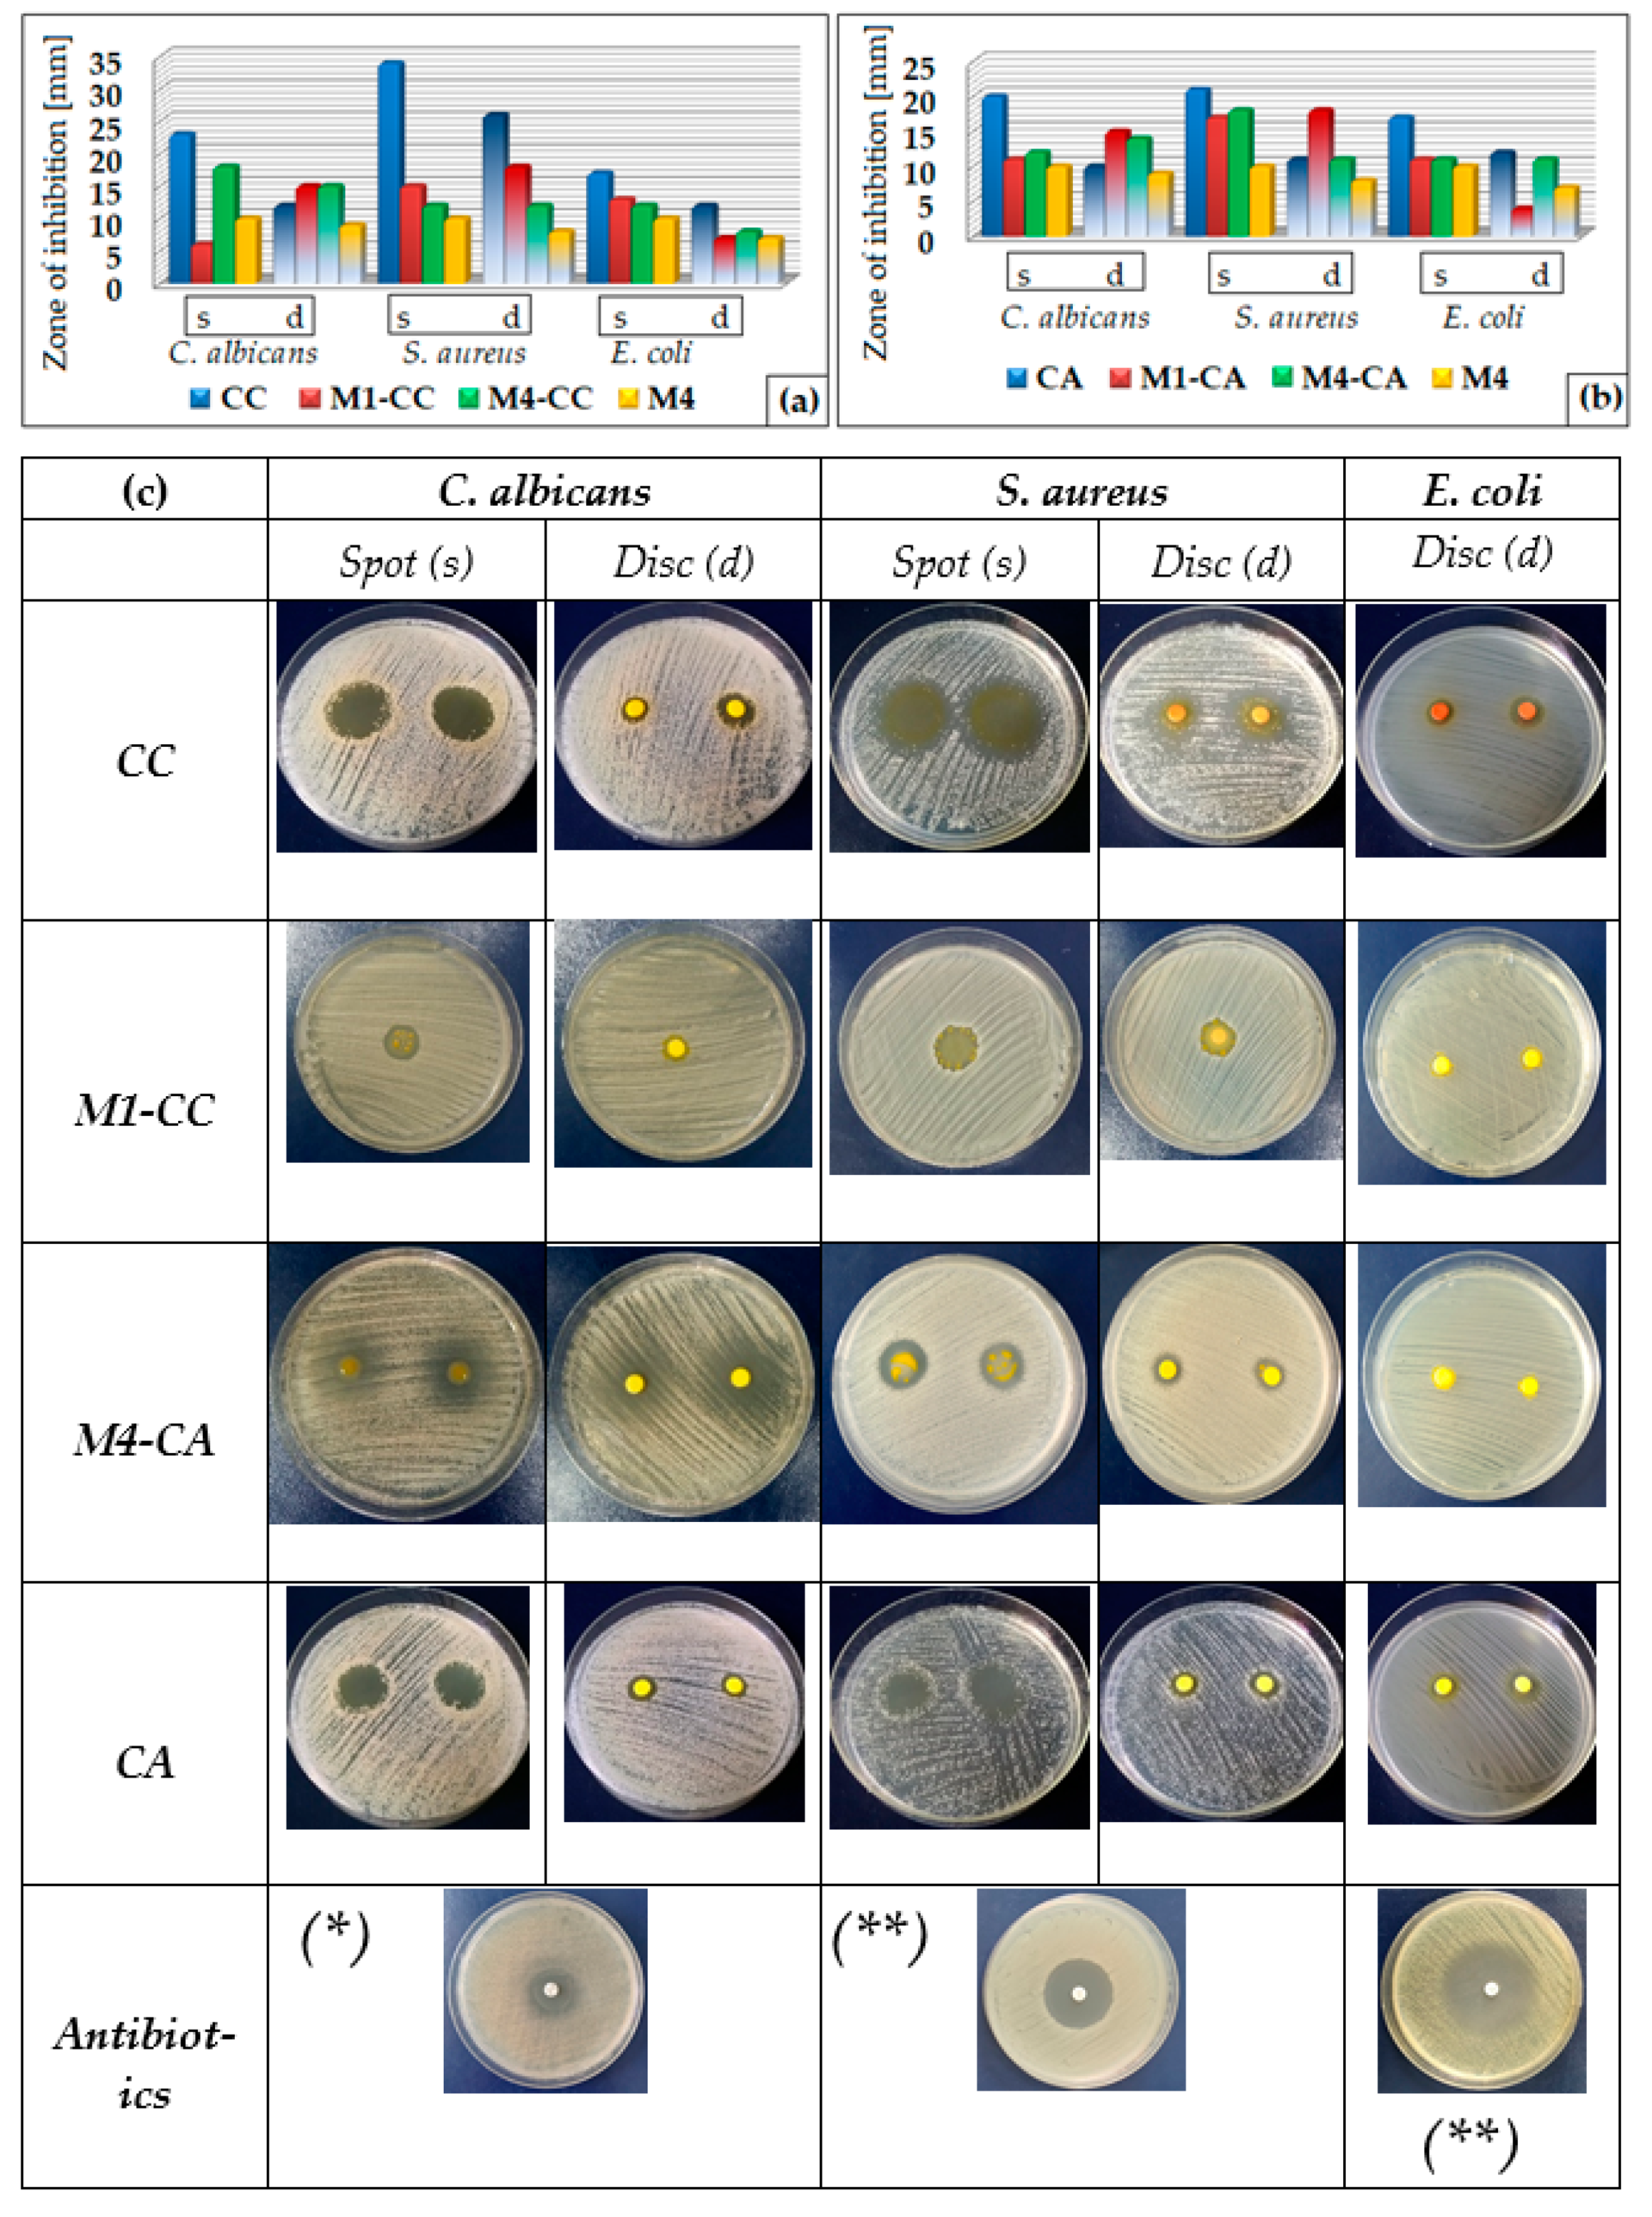
Materials 15 00267 g010

Modeling the Properties of Curcumin Derivatives in Relation to the Architecture of the Siloxane Host Matrices
Abstract
1. Introduction
2. Materials and Methods
2.1. Materials
2.1.1. Curcumin Dyes
2.1.2. The Host Matrix
2.1.3. Microorganisms
2.2. Methods
2.2.1. Obtaining the Mixture of Film-Forming Materials
2.2.2. Characterization Methods
3. Results
3.1. Morphological Characterization of Host Matrices and Composite Materials
3.1.1. Characterization of Host Matrices by ATR-FTIR Spectra
3.1.2. Thermogravimetric Analysis of Composite Materials
3.1.3. Determination of the Morphological Properties of Nanocoatings by AFM
3.1.4. Contact Angle Measurements
3.2. Photophysical Properties of Nanocomposite Coatings
3.2.1. Fluorescent Properties of Nanocomposites Deposited on Glass/PET Supports
3.2.2. Spectrophotometric Properties of Nanocomposites Deposited on Glass/PET Support
3.2.3. Study of the Antimicrobial Activity of Nanocomposites
4. Discussion
5. Conclusions
Author Contributions
Funding
Institutional Review Board Statement
Informed Consent Statement
Data Availability Statement
Conflicts of Interest
References
- Jennings, M.R.; Parks, R.J. Curcumin as an antiviral agent. Viruses 2020, 12, 1242. [Google Scholar] [CrossRef]
- Mathew, D.; Hsu, W.L. Antiviral potential of curcumin. J. Funct. Foods 2018, 40, 692–699. [Google Scholar] [CrossRef]
- Moghadamtousi, S.Z.; Kadir, H.A.; Hassandarvish, P.; Tajik, H.; Abubakar, S.; Zandi, K. A review on antibacterial, antiviral, and antifungal activity of curcumin. BioMed Res. Int. 2014, 12. [Google Scholar] [CrossRef]
- Priyadarsini, K.I. The chemistry of curcumin: From extraction to therapeutic agent. Molecules 2014, 19, 20091–20112. [Google Scholar] [CrossRef]
- Suresh, K.; Nangia, A. Curcumin: Pharmaceutical solids as a platform to improve solubility and bioavailability. Cryst. Eng. Comm. 2018, 20, 3277–3296. [Google Scholar] [CrossRef]
- Shin, G.H.; Li, J.; Cho, J.H.; Kim, J.T.; Park, H.J. Enhancement of curcumin solubility by phase change from crystalline to amorphous in Cur-TPGS nanosuspension. J. Food Sci. 2016, 81, 2. [Google Scholar] [CrossRef]
- Al-Akayleh, F.; Al-Naji, I.; Adwan, S.; Al-Remawi, M.; Shubair, M. Enhancement of curcumin solubility using a novel solubilizing polymer soluplus. J. Pharm. Innov. 2020. [Google Scholar] [CrossRef]
- Nagy, N.Z.; Varga, Z.; Mihály, J.; Domján, A.; Fenyvesi, É.; Kiss, É. Highly enhanced curcumin delivery applying association type nanostructures of block copolymers, cyclodextrins and polycyclodextrins. Polymers 2020, 12, 2167. [Google Scholar] [CrossRef]
- Chakraborty, S.; Ilagan, A.P.D. Chitosan curcumin film as a sensor for detection of o-nitrophenol and fluoride ion using fluoresce quenching technique. Philipp. J. Sci. 2020, 149, 27–33. [Google Scholar]
- Khorasani, M.Y.; Langari, H.; Sany, S.B.T.; Rezayi, M.; Sahebkar, A. The role of curcumin and its derivatives in sensory applications. Mater. Sci. Eng. C 2019, 103, 109792. [Google Scholar] [CrossRef]
- Lal, S.; Prakash, K.; Khera, N.; Drashya; Singh, S.; Singh, A.; Hooda, S.; Chandra, R. Curcumin based supramolecular ensemble for optical detection of Cu2+ and Hg2+ ions. J. Mol. Struct. 2020, 1211, 128091. [Google Scholar] [CrossRef]
- Supharoek, S.; Ponhong, K.; Siriangkhawut, W.; Grudpan, K. Employing natural reagents from turmeric and limefor acetic acid determination in vinegar sample. J. Food Drug Anal. 2018, 26, 583–590. [Google Scholar] [CrossRef]
- Chen, H.; Zhang, M.; Bhandari, B.; Yang, C. Novel pH-sensitive films containing curcumin and anthocyanins to monitor fish freshness. Food Hydrocoll. 2020, 100, 105438. [Google Scholar] [CrossRef]
- Suresha, S.; Kandasamy, M.; Kumar, S.K.; Murugesan, S. Photovoltaic performance of curcumin as sensitizer in a solid-state solar cell. Optik 2015, 126, 3366–3370. [Google Scholar] [CrossRef]
- Suyitno, S.; Agustia, Y.V.; Hidajat, L.L.G.; Kristiawan, B.; Wibowo, A.H. Effect of light and temperature on the efficiency and stability of curcumin-dye-sensitized solar cells. Int. Energy J. 2018, 18, 53–60. [Google Scholar]
- Ayoub, J.P.; Tractz, G.T.; Dias, B.V.; Banczek, E.P.; Rodrigues, P.R.P. Comparative study of Curcuma Longa and beta extracted dye applied on dye sensitized solar cells. Rev. Virtual Quim. 2019, 11, 1908–1919. [Google Scholar] [CrossRef]
- Castro, E.; Ceron, M.R.; Garcia, A.H.; Kim, Q.; Etcheverry-Berrıos, A.; Morel, M.J.; Dıaz-Torres, R.; Qian, W.; Martinez, Z.; Mendez, L.; et al. A new family of fullerene derivatives: Fullerenecurcumin conjugates for biological and photovoltaic applications. RSC Adv. 2018, 8, 41692. [Google Scholar] [CrossRef]
- Marcolino, V.A.; Zanin, G.M.; Durrant, L.R.; Benassi, M.T.; Matioli, G. Interaction of Curcumin and Bixin with β-Cyclodextrin: Complexation methods, stability, and applications in food. J. Agric. Food Chem. 2011, 59, 3348–3357. [Google Scholar] [CrossRef]
- Deng, Y.; Xi, L.; Songa, G.L.; Zhao, Y.; Zhang, Y.; Xu, Y.; Zheng, D. Development of a curcumin-based antifouling and anticorrosion sustainable polybenzoxazine resin composite coating. Compos. B Eng. 2021, 225, 109263. [Google Scholar] [CrossRef]
- Chen, L.; Song, Z.; Zhi, X.; Du, B. Photoinduced antimicrobial activity of curcumin-containing coatings: Molecular interaction, stability and potential application in food decontamination. ACS Omega 2020, 5, 31044–31054. [Google Scholar] [CrossRef]
- El-Hady, M.M.A.; Farouk, A.; Saeed, S.E.S.; Zaghloul, S. Antibacterial and UV protection properties modified cotton fabric using curcumin/TiO2 nanocomposite for medical textile applications. Polymers 2021, 13, 4027. [Google Scholar] [CrossRef] [PubMed]
- Alehosseini, A.; Gómez-Mascaraque, L.G.; Martínez-Sanz, M.; López-Rubio, A. Electrospun curcumin-loaded protein nanofiber mats as active/bioactive coatings for food packaging applications. Food Hydrocoll. 2019, 87, 758–771. [Google Scholar] [CrossRef]
- Schuhladen, K.; Roether, J.A.; Boccaccinia, A.R. Bioactive glasses meet phytotherapeutics: The potential of natural herbal medicines to extend the functionality of bioactive glasses. Biomaterials 2019, 217, 119288. [Google Scholar] [CrossRef]
- Kargozar, S.; Montazerian, M.; Hamzehlou, S.; Kim, H.W.; Baino, F. Mesoporous bioactive glasses: Promising platformsfor antibacterial strategies. Acta Biomater. 2018, 81, 1–19. [Google Scholar] [CrossRef] [PubMed]
- Martakov, I.S.; Shevchenko, O.G. Synthesis and enhanced antioxidant and membrane-protective activity of curcumin@AlOOH nanoparticles. J. Inorg. Biochem. 2020, 210, 111168. [Google Scholar] [CrossRef] [PubMed]
- Liu, J.; Wang, H.; Wang, P.; Guo, M.; Jiang, S.; Li, X.; Jiang, S. Films based on k-carrageenan incorporated with curcumin for freshness monitoring. Food Hydrocoll. 2018, 83, 134–142. [Google Scholar] [CrossRef]
- Naumova, K.A.; Dement’eva, O.V.; Senchikhin, I.N.; Rudoy, V.M. Mesoporous silica particles based on complex micelles of poorly water-soluble compounds. One simple step to multidrug carriers. Microporous Mesoporous Mater. 2021, 316, 110911. [Google Scholar] [CrossRef]
- Zhang, Y.; Li, W.; Liu, D.; Ge, Y.; Zhao, M.; Zhu, X.; Li, W.; Wang, L.; Zheng, T.; Li, J. Oral curcumin via hydrophobic porous silicon carrier: Preparation, characterization, and toxicological evaluation in vivo. ACS Appl. Mater. Interfaces 2019, 11, 31661–31670. [Google Scholar] [CrossRef]
- Ma, Q.; Dua, L.; Wang, L. Tara gum/polyvinyl alcohol-based colorimetric NH3 indicator films incorporating curcumin for intelligent packaging. Sens. Actuators B 2017, 244, 759–766. [Google Scholar] [CrossRef]
- Cheng, C.S.; Liu, T.P.; Chien, F.C.; Mou, C.Y.; Wu, S.H.; Chen, Y.P. Codelivery of plasmid and curcumin with mesoporous silica nanoparticles for promoting neurite outgrowth. ACS Appl. Mater. Interfaces 2019, 11, 15322–15331. [Google Scholar] [CrossRef] [PubMed]
- Raduly, F.M.; Raditoiu, V.; Raditoiu, A.; Purcar, V. Curcumin: Modern applications for a versatile additive. Coatings 2021, 11, 519. [Google Scholar] [CrossRef]
- El-Sayed, M.I.; Shalaby, T.I. Production of processed cheese supplemented with curcumin nanoemulsion. AJCN 2021, 9, 96–105. [Google Scholar] [CrossRef]
- Partovi, R.; Seifi, S.; Pabast, M.; Babaei, A. Effects of dietary supplementation with nanocurcumin on quality and safety of meat from broiler chicken infected with Eimeria species. J. Food Saf. 2019, 39, 12703. [Google Scholar] [CrossRef]
- Zheng, B.; McClements, D.J. Formulation of more efficacious curcumin delivery systems using colloid science: Enhanced solubility, stability, and bioavailability. Molecules 2020, 25, 2791. [Google Scholar] [CrossRef]
- Barbinta-Patrascu, M.E.; Gorshkova, Y.; Ungureanu, C.; Badea, N.; Bokuchava, G.; Lazea-Stoyanova, A.; Bacalum, M.; Zhigunov, A.; Petrovic, S. Characterization and antitumoral activity of biohybrids based on Turmeric and silver/silver chloride nanoparticles. Materials 2021, 14, 4726. [Google Scholar] [CrossRef] [PubMed]
- Freitas, C.F.; Kimura, E.; Rubira, A.F.; Muniz, E.C. Curcumin and silver nanoparticles carried out from polysaccharide-based hydrogels improved the photodynamic properties of curcumin through metal-enhanced singlet oxygen effect. Mater. Sci. Eng. C 2020, 112, 110853. [Google Scholar] [CrossRef]
- Aitah, K.A.; Lojkowski, W. Delivery of natural agents by means of mesoporous silica nanospheres as a promising anticancer strategy. Pharmaceutics 2021, 13, 143. [Google Scholar] [CrossRef]
- Kuang, G.; Zhang, Q.; He, S.; Liu, Y. Curcumin-loaded PEGylated mesoporous silica nanoparticles for effective photodynamic therapy. RSC Adv. 2020, 10, 24624. [Google Scholar] [CrossRef]
- Adamczak, A.; Ozarowski, M.; Karpinski, T.M. Curcumin, a natural antimicrobial agent with strain-specific activity. Pharmaceuticals 2020, 13, 153. [Google Scholar] [CrossRef]
- Li, B.; Pan, T.; Lin, H.; Zhou, Y. The enhancing antibiofilm activity of curcumin on Streptococcus mutans strains from severe early childhood caries. Microbiology 2020, 20, 286. [Google Scholar] [CrossRef]
- Subtaweesin, C.; Woraharn, W.; Taokaew, S.; Chiaoprakobkij, N.; Sereemaspun, A.; Phisalaphong, M. Characteristics of curcumin-loaded bacterial cellulose films and anticancer properties against malignant melanoma skin cancer cells. Appl. Sci. 2018, 8, 1188. [Google Scholar] [CrossRef]
- Sajjad, W.; He, F.; Ullah, M.W.; Ikram, M.; Shah, S.M.; Khan, R.; Khan, T.; Khalid, A.; Yang, G.; Wahid, F. Fabrication of bacterial cellulose-curcumin nanocomposite as a novel dressing for partial thickness skin burn. Front. Bioeng. Biotechnol. 2020, 15. [Google Scholar] [CrossRef]
- Roy, S.; Rhim, J.W. Antioxidant and antimicrobial poly(vinyl alcohol)-based films incorporated with grapefruit seed extract and curcumin. J. Environ. Chem. Eng. 2021, 9, 104694. [Google Scholar] [CrossRef]
- Barros, C.H.N.; Devlin, H.; Hiebner, D.W.; Vitale, S.; Quinn, L.; Casey, E. Enhancing curcumin’s solubility and antibiofilm activity via silica surface modification. Nanoscale Adv. 2020, 2, 1694. [Google Scholar] [CrossRef]
- Dias, L.D.; Blanco, K.C.; Mfouo-Tynga, I.S.; Inada, N.M.; Bagnato, V.S. Curcumin as a photosensitizer: From molecular structure to recent advances in antimicrobial photodynamic therapy. J. Photochem. Photobiol. C Photochem. Rev. 2020, 45, 100384. [Google Scholar] [CrossRef]
- Rachtanapun, P.; Klunklin, W.; Jantrawut, P.; Jantanasakulwong, K.; Phimolsiripol, Y.; Seesuriyachan, P.; Leksawasdi, N.; Chaiyaso, T.; Ruksiriwanich, W.; Phongthai, S.; et al. Characterization of chitosan film incorporated with curcumin extract. Polymers 2021, 13, 963. [Google Scholar] [CrossRef]
- Hanafi; Sirait, S.M.; Irawan, C.; Rochaeni, H. Poly(lactic acid) packaging modified curcumin as bioactive substance in tea drink (Camelia sinensis). Asian J. Chem. 2018, 30, 145–147. [Google Scholar] [CrossRef]
- Aliabbasi, N.; Fathi, M.; Emam-Djomeh, Z. Curcumin: A promising bioactive agent for application in food packaging systems. J. Environ. Chem. Eng. 2021, 9, 105520. [Google Scholar] [CrossRef]
- Qiao, Y.; Duan, L. Curcumin-loaded polyvinyl butyral film with antibacterial activity. e-Polymers 2020, 20, 673–681. [Google Scholar] [CrossRef]
- Singh, R.; Verma, K.; Kumar, R. Core–shell Ag-ZnO/Curcumin nanocomposite having optically active, thermally stable, hydrophilic surfaces for self cleaning applications. Appl. Phys. A 2020, 126, 1–15. [Google Scholar] [CrossRef]
- Marchisio, D.L.; Omegna, F.; Barresi, A.A.; Bowen, P. Effect of mixing and other operating parameters in sol-gel processes. Ind. Eng. Chem. Res. 2008, 47, 19. [Google Scholar] [CrossRef][Green Version]
- Schottner, G. Hybrid sol-gel-derived polymers: Applications of multifunctional materials. Chem. Mater. 2001, 13, 3422–3435. [Google Scholar] [CrossRef]
- Raditoiu, A.; Raditoiu, V.; Raduly, F.M.; Ispas, G.C.; Purcar, V.; Frone, A.N.; Manea, R.; Wagner, L.E.; Anastasescu, M. Fluorescent silica hybrid film-forming materials based on salicylaldazine. Coatings 2020, 10, 1255. [Google Scholar] [CrossRef]
- Wang, S.D.; Luo, S.S. Fabrication of transparent superhydrophobic silica-based film on a glass substrate. Appl. Surf. Sci. 2012, 258, 5443–5450. [Google Scholar] [CrossRef]
- Eo, Y.J.; Kim, D.J.; Bae, B.S. Coating of tetraethylorthosilicate (TEOS)/vinyltriethoxysilane (VTES) hybrid solution on polymer films. J Solgel Sci Technol. 1998, 13, 409–413. [Google Scholar] [CrossRef]
- Dehghanghadikolaei, A.; Ansary, J.; Ghoreishi, R. Sol-gel process applications: A mini-review. Proc. Natl. Acad. Sci. USA 2018, 2, 02008. [Google Scholar] [CrossRef]
- Quetzeri-Santiago, M.A.; Castrejón-Pita, A.A.; Castrejón-Pita, J.R. The efect of surface roughness on the contact line and splashing dynamics of impacting droplets. Sci. Rep. 2019, 9, 15030. [Google Scholar] [CrossRef] [PubMed]
- Huhtamäki, T.; Tian, X.; Korhonen, J.T.; Ras, R.H.A. Surface-wetting characterization using contact-angle measurements. Nat. Protoc. 2018, 13, 1521–1538. [Google Scholar] [CrossRef]
- Yang, X.; Zhu, L.; Chen, Y.; Bao, B.; Xu, J.; Zhou, W. Controlled hydrophilic/hydrophobic property of silica films by manipulating the hydrolysis and condensation of tetraethoxysilane. Appl. Surf. Sci. 2016, 376, 1–9. [Google Scholar] [CrossRef]
- Jeronimo, P.C.A.; Araujo, A.N.; Conceicao, M.; Montenegro, B.S.M. Optical sensors and biosensors based on sol–gel films. Talanta 2007, 72, 13–27. [Google Scholar] [CrossRef]
- Corsini, F.; Tatsi, E.; Colombo, A.; Dragonetti, C.; Botta, C.; Turri, S.; Griffini, G. Highly emissive fluorescent silica-based core/shell nanoparticles for efficient and stable luminescent solar concentrators. Nano Energy 2020, 80, 1–23. [Google Scholar] [CrossRef]
- Hadi, A.; Bahram, M.; Hossein, R.; Mansoor, N. New sol-gel solution with 45 days stability for preparation silica thin films. Iran. J. Chem. Chem. Eng. 2007, 26, 3. [Google Scholar]
- Raduly, M.F.; Raditoiu, V.; Raditoiu, A.; Wagner, L.E.; Amariutei, V.; Ailiesei Darvaru, G. Facile synthesis of curcumin and curcuminoid-like derivatives at microwaves. Rev. Chim. 2018, 69, 1327–1331. [Google Scholar] [CrossRef]
- Alven, S.; Nqoro, X.; Aderibigbe, B.A. Polymer-based materials loaded with curcumin for wound healing applications. Polymers 2020, 12, 2286. [Google Scholar] [CrossRef]
- Sharifi, S.; Fathi, N.; Memar, M.Y.; Khatibi, S.M.H.; Khalilov, R.; Negahdari, R.; Vahed, S.Z.; Dizaj, S.M. Anti-microbial activity of curcumin nanoformulations: New trends and future perspectives. Phytother. Res. 2020, 34, 1926–1946. [Google Scholar] [CrossRef]
- Deshmukh, K.; Kovarık, T.; Krenek, T.; Docheva, D.; Stich, T.; Pola, J. Recent advances and future perspectives of sol–gel derived porous bioactive glasses: A review. RSC Adv. 2020, 10, 33782. [Google Scholar] [CrossRef]
- Adlhart, C.; Verran, J.; Azevedo, N.F.; Olmez, H.; Keinanen-Toivola, M.M.; Gouveia, I.; Melo, L.F.; Crijns, F. Surface modifications for antimicrobial effects in the healthcare setting: A critical overview. J. Hosp. Infect. 2018, 99, 239–249. [Google Scholar] [CrossRef]
- Gong, Y.; Liu, W.; Huang, X.; Hao, L.; Li, Y.; Sun, S. Antifungal activity and potential mechanism of N-butylphthalide alone and in combination with Fluconazole against Candida albicans. Front. Microbiol. 2019, 10, 1461. [Google Scholar] [CrossRef]
- Sharma, P.C.; Jain, A.; Jain, S.; Pahwa, R.; Yar, M.S. Ciprofloxacin: Review on developments in synthetic, analytical, and medicinal aspects. J. Enzyme Inhib. Med. Chem. 2010, 25, 577–589. [Google Scholar] [CrossRef] [PubMed]

| Materials | TEOS [mL] | PTES [mL] | DPDMES [mL] | EtOH [mL] | THF [mL] | HCl [mL] | Dye (CC/CA) [g] | |
|---|---|---|---|---|---|---|---|---|
| Films | ||||||||
| M1 | 1.5 | 1.5 | 2.2 | 2 | 0.1 | |||
| M1-Dye | 1.5 | 1.5 | 2.2 | 2 | 0.1 | 0.02 | ||
| M2 | 0.3 | 1.5 | 1.2 | 2.2 | 2 | 0.1 | ||
| M2-Dye | 0.3 | 1.5 | 1.2 | 2.2 | 2 | 0.1 | 0.02 | |
| M3 | 0.3 | 2.1 | 0.6 | 2.2 | 2 | 0.1 | ||
| M3-Dye | 0.3 | 2.1 | 0.6 | 2.2 | 2 | 0.1 | 0.02 | |
| M4 | 2.4 | 0.6 | 2.2 | 2 | 0.1 | |||
| M4-Dye | 2.4 | 0.6 | 2.2 | 2 | 0.1 | 0.02 | ||
| Sample | RT-120 °C | 120–350 °C | 350–540 °C | 540–700 °C | Residue at 700 °C | ||||
|---|---|---|---|---|---|---|---|---|---|
| Wt. Loss | Wt. Loss | Tmax | Wt. Loss | Tmax | Wt. Loss | Tmax | N2 | Air | |
| (%) | (%) | (°C) | (%) | (°C) | (%) | (°C) | (%) | (%) | |
| M1-CA | 3.23 | 4.14 | 370.3 | 3.95 | 10.53 | 618.7 | 78.13 | 58.32 | |
| M1-CC | 3.14 | 4.32 | 177.0 | 5.57 | 490.5 | 9.89 | 607.5 | 77.09 | 58.79 |
| M2-CC | 0.27 | 8.19 | 274.4 | 35.55 | 509.0 | 12.37 | 599.3 | 43.61 | 26.38 |
| M3-CC | 0.30 | 5.90 | 283.0 | 11.40 | 466.4 | 15.79 | 589.2 | 66.61 | 40.06 |
| M4-CC | 0.31 | 7.92 | 282.9 | 63.76 | 500.7 | 6.28 | 598.5 | 21.75 | 12.30 |
| CC | 4.71 | 7.25 | 261.6 | 30.53 | 327.5 | 5.91 | 51.60 | 12.51 | |
| CA | 3.26 | 7.91 | 296.2 | 36.73 | 383.5 | 7.16 | 44.94 | 0.39 | |
| Film Sample (Dye Concentration, %) | Glass Support | PET Support | ||
|---|---|---|---|---|
| R550 (%) | T550 (%) | R550 (%) | T550 (%) | |
| Support | 10.3 | 91 | 12 | 85 |
| M2 | 11.4 | 88 | 11.4 | 84 |
| M2-CC (100%) | 11.3 | 89 | 11.3 | 81 |
| M2-CC (50%) | 11.2 | 89 | 11.2 | 86 |
| M2-CC (25%) | 11.2 | 90 | 11.2 | 86 |
| M2-CA (50%) | 11.6 | 90 | 11.3 | 85 |
| M2-CA (25%) | 11.6 | 90 | 11.3 | 85 |
Publisher’s Note: MDPI stays neutral with regard to jurisdictional claims in published maps and institutional affiliations. |
© 2021 by the authors. Licensee MDPI, Basel, Switzerland. This article is an open access article distributed under the terms and conditions of the Creative Commons Attribution (CC BY) license (https://creativecommons.org/licenses/by/4.0/).
Share and Cite
Raduly, F.M.; Rădiţoiu, V.; Rădiţoiu, A.; Frone, A.N.; Nicolae, C.A.; Purcar, V.; Ispas, G.; Constantin, M.; Răut, I. Modeling the Properties of Curcumin Derivatives in Relation to the Architecture of the Siloxane Host Matrices. Materials 2022, 15, 267. https://doi.org/10.3390/ma15010267
Raduly FM, Rădiţoiu V, Rădiţoiu A, Frone AN, Nicolae CA, Purcar V, Ispas G, Constantin M, Răut I. Modeling the Properties of Curcumin Derivatives in Relation to the Architecture of the Siloxane Host Matrices. Materials. 2022; 15(1):267. https://doi.org/10.3390/ma15010267
Chicago/Turabian StyleRaduly, Florentina Monica, Valentin Rădiţoiu, Alina Rădiţoiu, Adriana Nicoleta Frone, Cristian Andi Nicolae, Violeta Purcar, Georgiana Ispas, Mariana Constantin, and Iuliana Răut. 2022. "Modeling the Properties of Curcumin Derivatives in Relation to the Architecture of the Siloxane Host Matrices" Materials 15, no. 1: 267. https://doi.org/10.3390/ma15010267
APA StyleRaduly, F. M., Rădiţoiu, V., Rădiţoiu, A., Frone, A. N., Nicolae, C. A., Purcar, V., Ispas, G., Constantin, M., & Răut, I. (2022). Modeling the Properties of Curcumin Derivatives in Relation to the Architecture of the Siloxane Host Matrices. Materials, 15(1), 267. https://doi.org/10.3390/ma15010267

